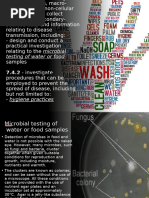

FACTS AND PREVENTION TIPS FOR CHOLERA
Cholera outbreaks are not common in Vietnam, but
small scale outbreaks sometimes do occur, usually
in coastal areas / provinces. The infection is usually
related to eating food (uncooked seafood, shrimp pastes,
dirty ice, ice cream, or drinking contaminated water).5
WHAT IS CHOLERA?
\ The bacteria Vibrio cholera can survive in water and
in food and is easily killed by heat and by normal
disinfectants.
\ Background data
• In the environment, Vibrio cholera may be able to survive up to 39
days in industrially-polluted water 1, up to 30 days in fresh water,
up to 5 days in crops, and up to 120 days in soil 2.
• In foods, Vibrio cholera survived as long as 14 days in raw milk,
fish and vegetables under moderate refrigeration conditions up
to 10oC. Survival at ambient temperatures was decreased.3
• The bacteria will be killed in less that 5 minutes at 80oC and
killed immediately at boiling temperatures (100oC).4
• The bacterial is sensitive to sanitizers (calcium chloride,
cresol, phenol) and acid (e.g., chlohydric acid).5
HOW IS THE CHOLERA BACTERIA TRANSMITTED?
\ Water borne transmission (usually leading to mass scale outbreaks).
\ Transmitted via food, contact with contaminated hands and/or infected articles, and pests.
\ Transmitted by the patients and their contaminated articles.
• Touching an infected human
• Touching an object that an infected human touched
GENERAL CHOLERA PREVENTION METHODS
\ Medical
• The World Health Organization recommends prompt administration of oral rehydration salts under care of
medical professionals as the primary treatment.
• Medicines – Azithromycine and Chloramphenicol, used as prescribed by medical professionals.6
\ Non-Medical – Personal hygiene
• Stay home when you are sick and get plenty of rest.
• Seek immediate medical evaluation in the event of watery diarrhea. Do not self-treat.
• Avoid touching eyes, nose and mouth (Bacteria are often spread when a person touches
something that is contaminated and then touches his/her eyes, nose or mouth).
• Properly cover your mouth and nose with a tissue or sleeve when coughing or sneezing.
• Ill people should not prepare food.
1 http://www.wrc.org.za/archives/watersa%20archive/2004/Jan-04/10.pdf
2 http://www.epa.gov/OWM/mtb/comp.pdf
3 International Commission on Microbiological Specifications for Foods. Microorganisms in Foods 5,
Microbiological Specifications of Food Pathogens. Blackie Academic and Professional, New York. 1996.
4 International Commission on Microbiological Specifications for Foods. Microorganisms in Foods 5,
Microbiological Specifications of Food Pathogens. Blackie Academic and Professional, New York. 1996.
5 http://www.medinet.hochiminhcity.gov.vn/data/news/2007/11/5199/4178_phong_chong_ta_trong_benh_vien.pdf
6 http://www.medinet.hochiminhcity.gov.vn/data/news/2007/11/5196/chan_doan_dieu_tri_ta.pdf
�GENERAL CHOLERA PREVENTION METHODS (continued)
\ Hand hygiene
• Use anti-microbial hand soaps.
• Wash hands before eating and after using the toilet, before handling food, after handling soiled equipment or
utensils, and after engaging in other activities that contaminate the hands.
• Use proper hand washing procedures:
• Wet hand with warm water.
• Apply soap to hands.
• Rub hands together vigorously for 15-20 seconds, covering all surfaces of hands and fingers.
• Rinse hands with warm water.
• Thoroughly dry hands with disposable towel or air blower.
• Use towel to turn off faucet.
• Sanitize hands frequently with an alcohol rub / gel.
• Use proper hand sanitizing procedures:
• Apply product to palm.
• Rub hands together covering all surfaces of hands and fingers.
• Rub until dry (15-20 seconds).
• Use on visibly clean hands.
• Consider offering in public areas.
\ Environment sanitation
• Clean and disinfect all hard surfaces and the surfaces where food is processed.
• Clean: Organic material could protect the bacteria from sanitizers. Removal of the organic material is a
key part of effective disinfection.
• Rinse: Detergents should be rinsed off to avoid dilution or inactivation of disinfectant.
• Disinfect: Follow directions for use on the product label of a properly EPA registered disinfectant.
• Wipe down frequently-touched surfaces with a properly registered disinfectant.
• Light and air control switches.
• Faucets and toilet flush levers.
• Door knobs, TV and radio controls and telephones.
• Public restroom doors.
• Other surfaces as needed.
• Disinfect all surfaces in the bathroom that may have contacted respiratory secretions,
urine or feces according to standard infection control procedures.
• Implement food safety measures.
• Identify and dispose of all food items that have been associated with this outbreak
(such as: uncooked seafood, shrimp paste etc.).
• Avoid eating high risk food.
• Avoid raw seafood to minimize risk of household contamination.
• Thoroughly cook all food - apply “Boil it, cook it, peel it, or forget it” procedures
• Wash and disinfect raw fruits and vegetables
• Drink boiled water or bottled water
• Beverage and ice should be made from boiled or chlorinated water
www.ecolab.com
© 2007 Ecolab Inc. All rights reserved
Not for distribution in the U.S. or Canada
�ECOLAB PRODUCTS FOR CLEANING & DISINFECTING
ON HARD SURFACES AND HAND HYGIENE
CLEANING DISINFECTING
Oasis Compac Multi Purpose Cleaner Oasis Compac Quat Sanitizer
for all water-tolerant surfaces Quat-based disinfectant for food contact surfaces
Novasan Micro Quat / Ster-Bac / Triquart
Disinfecting cleaner for all hard surfaces, floors Quat-based disinfectant for hard surfaces
Topax 66 Trichlorocide XP-160 / XY-12
Chlorinated alkaline foam cleaner for hard surfaces Chlorine-based disinfectant
Oxonia Active
HAND HYGIENE
Peracetic-based disinfectant for food contact surfaces
Anti-Bacterial Clean and Smooth Hand Soap
Triclosan-based soap with disinfecting efficacy
Sanigizer Plus Contact Ecolab Vietnam for more specifications
Alcohol-based sanitizer gel for hand Phone: +84 (8) 812-5668 y +84 (4) 537-6205
Email: info.vietnam@ecolab.com
ADDITIONAL RESOURCES *
Ministry of Health, Vietnam
http://www.moh.gov.vn/homebyt/vn/portal/HomeArea.jsp?area=228
Department of Health, Hochiminh City
http://www.medinet.hochiminhcity.gov.vn/tintuc/news_detail.asp?period_id=1&cat_id=391&news_id=5188#content
Center of Disease Control
http://www.cdc.gov/ncidod/dbmd/diseaseinfo/cholera_g.htm
http://wwwn.cdc.gov/travel/yellowBookCh4-Diarrhea.aspx
http://www.cdc.gov/ncidod/dpd/parasites/diarrhea/factsht_chronic_diarrhea.htm
World Health Organization
http://www.who.int/water_sanitation_health/diseases/en/
http://www.who.int/topics/cholera/en/
Ecolab Inc. – Public health information
http://www.ecolab.com/PublicHealth/Vibrio.asp
* These recommendations are offered as a set of best practices to help
lower the probability of infecting by the cholera bacteria
www.ecolab.com
© 2007 Ecolab Inc. All rights reserved
Not for distribution in the U.S. or Canada
�ADDITIONAL INFORMATION
Cục Y Tế Dự Phòng: US Embassy Health Unit & CDC, Hanoi -
4 Khuyến Cáo Dành Cho Cộng Đồng Message on How to Reduce Exposure
Phòng Chống Bệnh Tiêu Chảy Cấp Nguy Hiểm
Bệnh Tiêu Chảy Cấp nguy hiểm lây lan nhanh và dễ tử The Government of Vietnam has confirmed a growing outbreak of
vong, nhưng có thể đề phòng được. Để ngăn ngừa acute diarrhea in the northern part of the nation. Some of the cases
bệnh và phòng dịch bệnh lây lan, mọi người thực hiện have been confirmed as cholera. The source of the outbreak is
những khuyến cáo sau: thought to be contaminated locally produced seafood. Implicated
foods include shrimp paste known as mam tom and possibly goi ca
1. Vệ sinh cá nhân, vệ sinh môi trường: (made of raw fish and vegetable) and fermented pork roll. The
Ministry of Health is undertaking active measures to contain this
\ Rửa tay bằng xà phòng trước khi ăn và sau khi đi outbreak. As of November 5, 2007, the outbreak has occurred in the
vệ sinh provinces north of and including Nghe An; however, the outbreak
\ Mỗi gia đình có một nhà tiêu hợp vệ sinh, cấm đi has the potential to spread to other areas of the country.
tiêu bừa bãi. Đối với gia đình có bệnh nhân tiêu According to the U.S. Embassy Health Unit, the illness can progress
chảy cấp cần rắc vôi bột hoặc Chloramine B sau rapidly to a severe state of dehydration, requiring hospitalization.
mỗi lần đi tiêu Preventive steps include hand washing; drinking boiled, filtered, or
\ Phân và chất thải của người bệnh phải đổ vào nhà bottled water; and eating only cooked foods.
tiêu, cho vôi bột, Cloramin B... vào sau mỗi lần đi
để sát khuẩn To reduce the risk of exposure the U.S. Centers For Disease
\ Tránh tập trung ăn uống đông người như ma chay, Control and Prevention (CDC) office in Hanoi and the U.S. Embassy
cưới xin, cúng giỗ Health Unit is strongly recommending compliance with the following
\ Hạn chế người ra, vào vùng đang có dịch measures:
1. Identify and dispose of all food items that have been
2. An toàn vệ sinh thực phẩm: associated with this outbreak (see above)
2. Avoid all seafood to minimize risk of household contamination
\ Hạn chế người ra, vào vùng đang có dịch
\ Mọi người, mọi nhà đều thực hiện ăn chín, uống sôi 3. Thoroughly cook all food. “Boil it, cook it, peel it, or forget it.”
\ Không ăn rau sống, không uống nước lã Travelers to cholera-affected areas should adhere to this
\ Không ăn các thức ăn dễ bị nhiễm khuẩn đặc biệt adage and avoid eating high-risk foods, especially fish and
là mắm tôm sống, hải sản tươi sống, gỏi cá, tiết shellfish. Food that is cooked and served hot, fruits and
canh, nem chua vegetables peeled by the traveler personally, beverages and
ice that are made from boiled or chlorinated water, and
3. Bảo vệ nguồn nước và dùng nước sạch: carbonated beverages are usually safe
\ Nguồn nước ăn uống phải được bảo vệ sạch 4. Maintain good hand hygiene during food preparation
\ Tất cả nước ăn uống đều phải được sát khuẩn 5. Exercise caution when eating foods locally prepared outside of
bằng hoá chất Chloramine B your home and avoid dishes containing seafood
\ Cấm đổ chất thải, nước giặt, rửa và đồ dùng của 6. In the event of watery diarrhea, seek an immediate medical
người bệnh xuống ao, hồ, sông, giếng. Cấm vứt evaluation. Do not self-treat with antibiotics or anti-motility
súc vật chết và rác xuống ao, hồ, sông, giếng medications (e.g., Lomotil or Immodium). Oral rehydration
solutions (a prepackaged mixture of sugar and salts to be
4. Khi có người bị tiêu chảy cấp: mixed with water and drunk in large amounts) are needed to
replenish immediate fluid loss from the diarrhea. However, you
\ Khi gia đình có người bị tiêu chảy cấp, phải nhanh should not delay an immediate medical evaluation. You may
chóng báo ngay cho cơ sở y tế nơi gần nhất để need intravenous fluids and other medication.
được điều trị kịp thời
Source: Cục Y Tế Dự Phòng
Preventive Health Department, 01/11/2007 Source: http://hochiminh.usconsulate.gov/diarrheaoutbreak.html